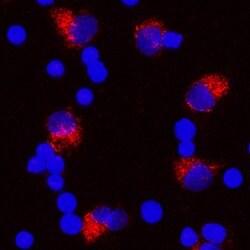
Human IL-1 beta/IL-1F2 Antibody, R D Systems:Antibodies:Primary Antibodies

missing translation for 'onlineSavingsMsg'
Learn More
Learn More
Human IL-1 beta/IL-1F2 Antibody, R&D Systems™


Mouse Monoclonal Antibody
245.00 € - 2000.00 €
Specifications
| Antigen | IL-1 beta/IL-1F2 |
|---|---|
| Clone | 2805R |
| Dilution | Western Blot 1 ug/mL, Simple Western 10 ug/mL, Neutralization 50-200 ng/mL, Immunocytochemistry 8-25 ug/mL, ELISA Capture (Matched Antibody Pair) 2-8 ug/mL |
| Applications | Western Blot, Neutralization, Immunocytochemistry, ELISA |
| Classification | Monoclonal |
| Product Code | Brand | Quantity | Price | Quantity & Availability | |||||
|---|---|---|---|---|---|---|---|---|---|
| Product Code | Marca | Quantity | Prezzo | Quantità e disponibilità | |||||
18795589
 |
R&D Systems
MAB601R-SP |
25 μg |
245.00 €
25µg |
Please sign in to purchase this item. Need a web account? Register with us today! | |||||
18778739
 |
R&D Systems
MAB601R-100 |
100 μg |
512.00 €
100µg |
Please sign in to purchase this item. Need a web account? Register with us today! | |||||
|
18116061
|
R&D Systems
MAB601R-01M |
1 mg |
1610.00 €
1mg |
Please sign in to purchase this item. Need a web account? Register with us today! | |||||
|
18132951
|
R&D Systems
MAB601R-500 |
500 ug |
2000.00 €
500µg |
Please sign in to purchase this item. Need a web account? Register with us today! | |||||
Descrizione
IL-1 beta/IL-1F2 Monoclonal specifically detects IL-1 beta/IL-1F2 in Human samples. It is validated for Western Blot, Simple Western, Neutralization, Immunocytochemistry, ELISA Capture (Matched Antibody Pair).Specifica
| IL-1 beta/IL-1F2 | |
| Western Blot 1 ug/mL, Simple Western 10 ug/mL, Neutralization 50-200 ng/mL, Immunocytochemistry 8-25 ug/mL, ELISA Capture (Matched Antibody Pair) 2-8 ug/mL | |
| Monoclonal | |
| Mouse | |
| Human | |
| 3553 | |
| Primary | |
| Use a manual defrost freezer and avoid repeated freeze-thaw cycles. 12 months from date of receipt, -20 to -70 degreesC as supplied. 1 month, 2 to 8 degreesC under sterile conditions after reconstitution. 6 months, -20 to -70 degreesC under sterile conditions after reconstitution. |
| 2805R | |
| Western Blot, Neutralization, Immunocytochemistry, ELISA | |
| Unconjugated | |
| RUO | |
| catabolin, IL-1, IL1 beta, IL-1 beta, IL-1b, IL1B, IL1-BETA, IL-1F2, IL1F2IL-1 beta, interleukin 1, beta, interleukin-1 beta, preinterleukin 1 beta, pro-interleukin-1-beta | |
| IgG1 | |
| Protein A or G purified from cell culture supernatant | |
| Detects human IL-1 beta/IL-1F2 in sandwich ELISAs and Western blots. In sandwich ELISAs, less than 4% cross-reactivity with recombinant rat (rr) IL-1 beta and less than 0.1% with recombinant porcine (rp) IL-1 beta , recombinant human IL-1 alpha , rpIL-1 alpha , rrIL-1 alpha , recombinant mouse (rm) IL-1 alpha , and rmIL-1 beta is observed. |
Individuate un'opportunità di miglioramento?Condividi una correzione di contenuto
Correzione del contenuto del prodotto
Fornite il vostro feedback sul contenuto del prodotto compilando il modulo sottostante.
Titolo del prodotto